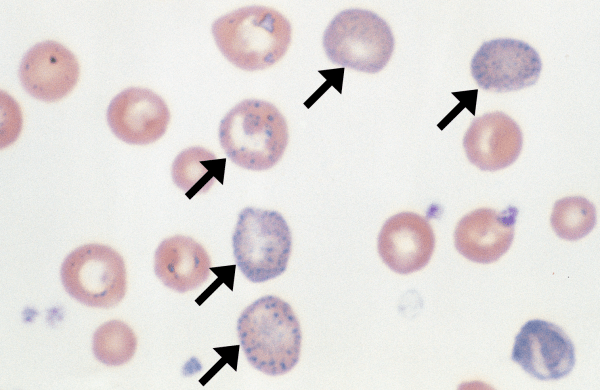

Metarubricyte: most mature form of nucleated red blood cell (nRBC). Nuclei are small and pyknotic, often eccentric, with condensed (smooth dark) chromatin. Cytoplasm is smooth and uniform and may stain… Read more Nucleated Red Blood Cells →

Morphology: numerous small, blue, punctate inclusions in red blood cells. Caused by spontaneous aggregation of ribosomes in the cytoplasm. Look alike: Mycoplasma Commonly seen with: features of regenerative anemia (macrocytes, anisocytosis, polychromatophils), features… Read more Basophilic Stippling →

Morphology: small, round, dark purple inclusions within red blood cells. Usually only 1 per red cell. Howell-Jolly bodies are nuclear remnants (small fragments of non-functional nucleus that were not expelled… Read more Howell-Jolly Bodies →

Morphology: dense round granules at the periphery of a red blood cell. Result from oxidant injury to red blood cells which causes hemoglobin to precipitate and form intracellular inclusions. Commonly seen… Read more Heinz Bodies →